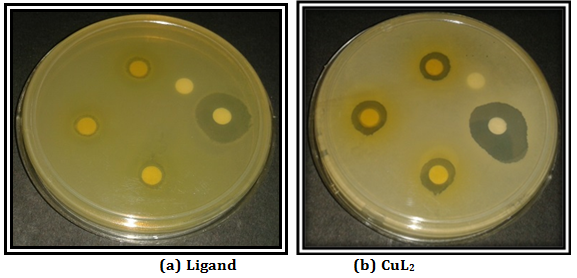
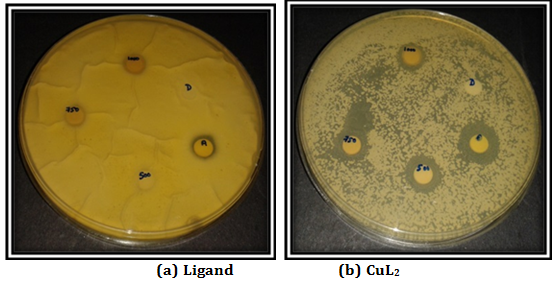

Int J Curr Pharm Res, Vol 8, Issue 3, 43-47Original Article
DNA CLEAVAGE, CYTOTOXIC ACTIVITIES, AND ANTIMICROBIAL STUDIES OF SOME NOVEL SCHIFF BASE TRANSITION METAL COMPLEXES DERIVED FROM 4-AMINOANTIPYRINE AND DIHYDROPYRIMIDONE OF VANILLIN
P. MANGAIYARKKARASI1*, S. ARULANTONY1,2
1R and D Centre, Department of Chemistry, Bharathiar University, Coimbatore 641046, TN, India, 2PG and Research Department of Chemistry, Presidency College, Chennai 600005, TN, India
Email: mangaisiva2011@gmail.com
Received: 21 Mar 2016, Revised and Accepted: 20 Jun 2016
ABSTRACT
Objective: A novel series of transition metal complexes of Ni(II), Zn(II), Cd(II) and Hg(II) have been synthesized from the Schiff base derived from dihydropyrimidone derivative of vanillin (Biginelli Product) and 4-aminoantipyrine.
Methods: The antimicrobial screening of the ligand and its complexes have been extensively studied on bacterias like E. coli, Vibrio spp., Staphylococcus aureus, Pseudomonas aeroginosa, Bacillus spp., Vibrio para haemolytic's, Salmonella spp., Aeromonas spp., Klebsiella spp., Proteus spp. and fungi such as Candida albicans, Aspergillus flavus, Pencillium spp., Aspergillus niger, Trichophyton.
Results: The metal complexes show greater activity than ligand. The antimicrobial activity of the complexes follows the order Hg<Zn<Cu. The DNA cleaving activity of Schiff base ligand and its metal complexes was examined using, Hep 2 DNA as a target molecule by gel electrophoresis method. The Cu Complex-induced the DNA fragmentation with a specific activity. The in vitro cytotoxic effect of ligand and complex against Normal VERO and Hep2 was evaluated by MTT assay.
Conclusion: The effect of [CuL2]Cl2 was found to be stronger than the other compounds even at its lower concentrations.
Keywords: 4-aminoantipyrine, Schiff base complexes, Antimicrobial, Anticancer, Cytotoxic, DNA Cleavage
© 2016 The Authors. Published by Innovare Academic Sciences Pvt Ltd. This is an open access article under the CC BY license (http://creativecommons.org/licenses/by/4.0/)
INTRODUCTION
Schiff bases are compounds containing C=N group which have been extensively studied for their biological activities [1]. Co-ordination of these Schiff bases with metal complexes enhances their biological activities. Bonding between M-N, M-O was found to be important for their activities as industrial, antifungal, antibacterial, anticancer, antiviral and herbicidal applications [2-6]. Moreover, 4-amino-antipyrine and dihydropyrimidones possessing heterocycle ring with ‘N’ atom, was found to be exhibit strong biological activities such as antibacterial, antifungal, antitumor activities. Transition metal complexes that are suitable for binding and cleaving double-stranded DNA are of considerable current interest due to their various applications [7-9]. Cleavage of DNA can be achieved by targeting its basic constituents like base and/or sugar by an oxidative pathway or by hydrolysis of phosphoester linkages. Iron and copper complexes are known to be useful for oxidative cleavage of DNA involving nucleobase oxidation and/or degradation of sugar by abstraction of deoxyribose hydrogen atom(s), while complexes containing strong Lewis acids like copper (II) and zinc(II) are suitable for hydrolytic cleavage of DNA. Oxidative cleavage of DNA could take place by chemical or photochemical means [10].
The Schiff base containing N2O2 donor groups and its metal complexes were synthesized and characterized by elemental analysis and spectral analysis. The synthesis and characterization of Schiff base ligand and their metal complexes are communicated in the research paper elsewhere [11, 12]. In the present study chelating agent and metal, chelates were used to study their effect on bacterial, fungal, cytotoxic activities and DNA cleavage.
MATERIALS AND METHODS
In vitro antimicrobial assay
The in vitro antimicrobial activity of synthesized Schiff base ligand (L) and its Cu, Zn, Hg complexes was assayed against two gram positive and eight-gram negative bacterial strains.
Antibacterial activity assay
Stock cultures were maintained at 4 °C on Nutrient agar Slant. Active cultures for experiments were prepared by transferring a loop full of culture from the stock cultures into the test tubes containing nutrient broth, that were incubated for 24 hrs at 37 ºC. The assay was performed by the agar disc diffusion method. Antibacterial activity of extracts was determined by disc diffusion method on Muller Hinton agar (MHA) medium [13]. Muller Hinton Agar (MHA) medium is poured into the Petri plate. After the medium was solidified, the inoculums were spread on the solid plates with a sterile swab moistened with the bacterial suspension (Staphylococcus aureus, Salmonella spp., E. coli, Vibrio spp., Pseudomonas aeroginosa, Vibrio parahaemolytics, Aeromonas spp., Klebsiella spp., Proteus spp., and Bacillus spp.,). The disc was placed in MHA plates and 20 µl of the samples (Concentration: 1000 µg, 750 µg and 500 µg) were placed in the disc. The plates were incubated at 37ºC for 24 hrs. Then the antimicrobial activity was determined by measuring the diameter of the zone of inhibition.
Antifungal activity assay
The Assay was performed by the agar disc diffusion method. The Antifungal activity of the extracts was determined by disc diffusion method on Sabouraud Dextrose agar (SDA) medium [14-16]. Sabouraud Dextrose agar (SDA) medium is poured into the Petri plate. After the medium had been solidified, the inoculums were spread on the solid plates with a sterile swab moistened with the fungal suspension (Candida albicans, Aspergillus flavus, Pencillium spp., Aspergillus niger, Trichophyton).
The disc was placed in SDA plates and added 20 µl of the sample (Concentration: 1000µg, 750µg and 500 µg) were placed in the disc. The plates were incubated at room temperature for 24 hrs. Then the antifungal activity was determined by measuring the diameter of the zone of inhibition.
Minimum inhibitory concentration (MIC)
Minimum Inhibitory Concentration (MIC) was defined as the lowest concentration of an antimicrobial that will inhibit the visible growth of a microorganism after overnight inhibition. Clinically MIC are used not only to determine the amount of antibiotic that the patient will receive also abut the type of antibiotic used, which in turn lowers the opportunity for microbial resistant to a specific antimicrobial agent. Applying MIC testing to a number of bacterial strains in the same species provides an estimate of the concentration that inhibits 50% and 90% of bacterial isolates and can indicate shifts in susceptibility of bacterial populations to antibiotic [17]. MIC of compounds was determined in nutrient agar plate by microdilution method according to the National Committee for clinical laboratory standards. Standardized suspension of test organisms (0.1 ml, 106cfu/ml) were placed in Petri plates. The Schiff base ligand its metal complexes were taken in petri plates. Ampicillin and Amphotericin B were used as positive control for bacterial and fungal strains and DMSO was used as a negative control for both the strains. The bacterial plates were incubated at 37 °C for 18 h and fungal plates were incubated at 32 °C for 48 h. The diameter Zone of inhibition inhibits the bacterial and fungal growth compared with the control was recorded as MIC.
DNA cleavage activity
In order to study whether the novel Schiff base ligand and its metal complexes could behave as DNA cleaving agents or not, they were examined using, Hep 2 DNA as a target molecule according to the literature method [18]. The cleavage activity of the test compounds was analyzed by gel electrophoresis method. About 0.5 ml of the cell was taken in a centrifuge cell and was centrifuged at 200xg at 4 °C for 10 mins. About 0.5 ml of TTE solution was added to the pellet and was vortexed vigorously. This procedure allowed the release of fragmented chromatin from nuclei, after cell lysis (due to the presence of Triton X-100 in the TTE solution) and distruption of the nuclear structure (following Mg2+chelating by EDTA method in the TTE solution). The tubes were centrifuged at 20,000xg for 10 min at 4 °C to separate fragmented DNA from intact chromatin. The supernatants were carefully removed, and about 500 µl of TTE solution was added into the pellet. About 500 µl of Ice-Cold %M NaCl was added and vortexed vigorously. The addition of salt should be able to remove histones from DNA. About 700 µl ice-cold isopropanol was added and vortexed vigorously. It was allowed to precipitate overnight at-20 °C. After precipitation DNA was recovered by pelleting for 10 min at 20,000xg at 4 °C. The pellets were rinsed by adding 500-700 µl of ice-cold 70% ethanol. The tubes were centrifuged at 20,000xg for 10 mins at 4 °C. DNA was dissolved by adding 20-50 µl of TE solution to each tube and was placed at 4 °C. The samples of DNA were mixed with loading buffer by adding 10x loading buffer to a final concentration of 1x. The addition of loading buffer to samples allowed to load in wells more easily and to monitor the run of samples. The electrophoresis was then run in standard TE buffer after setting the voltage to the desired level. During electrophoresis, the migration of samples by following the migration of bromophenol blue dye contained in the loading dye was monitored. The electrophoresis was stopped when the dye reached about 3 cm from the end of the gel. The gel was then placed on a UV Trans illuminator to visualize DNA and photographed to determine the extent of DNA cleavage, and the results were compared with those of a standard DNA marker.
In vitro cytotoxicity
The MTT assay has been chosen to evaluate the in vitro cytotoxic effect of the newly synthesized Schiff base (L) and its Cu (II), Hg(II), Zn(II) complexes. This is an efficient, rapid, inexpensive test and has a good correlation with cytotoxic activity [19].
Cell line and culture
Normal VERO and Hep2 cell lines were obtained from National Centre for Cell Sciences, Pune (NCCS). The cells were maintained in Minimal Essential Medium supplemented with 10% FBS, penicillin (100 U/ml), and streptomycin (100 μg/ml) in a humidified atmosphere of 50 μg/ml CO2 at 37 °C.
Reagents
MEM was purchased from Hi-Media Laboratories Fetal Bovine Serum (FBS) was purchased from Cistron laboratories Trypsin, methyl thiazolyl diphenyl tetrazolium bromide (MTT) and Dimethyl sulfoxide (DMSO) were purchased from (Sisco research laboratory chemicals Mumbai). All of other chemicals and reagents were obtained from Sigma-Aldrich Mumbai.
In vitro assay for anticancer activity (MTT assay) (Mosmann, 1983)
Cells (1 × 105/well) were plated in 24-well plates and incubated in 37 °C with 5% CO2 condition. After the cell reaches the confluence, the various concentrations of the samples were added and incubated for 24 hours. After incubation, the sample was removed from the well and washed with phosphate-buffered saline (pH 7.4) or MEM without serum. 100 µl/well (5 mg/ml) of 0.5% 3-(4,5-dimethyl-2-thiazolyl)-2,5-diphenyl--tetrazolium bromide (MTT) was added and incubated for 4 hours. After incubation, 1 ml of DMSO was added in all the wells. The absorbance at 570 nm was measured with UV-Spectrophotometer using DMSO as the blank. Measurements were performed and the concentration required for a 50% inhibition (IC50) was determined graphically. The % cell viability was calculated using the following formula:
% cell viability = A570 of treated cells/A570 of control cells × 100
Graphs are plotted using the % of Cell Viability at Y-axis and concentration of the sample in X-axis. Cell control and sample control is included in each assay to compare the full cell viability in Cytotoxicity and anti-cancer activity assessments.
RESULTS AND DISCUSSION
Effect of ligand and metal complexes on antimicrobial study
The data of the antibacterial and antifungal activities of ligand and complexes are given in table 1 and 2. The antimicrobial activity was determined by measuring the diameter of the zone of inhibition (fig. 1 and 2). The data reveals that the complexes have higher inhibitory activities than the free ligand. The enhancement of the activity of ligand on complexation can be explained by Overtone’s Concept and Chelation Theory [20]. This theory states that chelation reduces the polarity of the metal atom by the partial sharing of its positive charge with donor groups and possible π-electron delocalization over the whole ring. This results in increasing lipophilic character of the complex and favours the permeation of the complex through the lipid layer of the cell membrane. The complex blocks the metal binding sites in the enzymes of microorganisms. Consequently, the complex disturbs the metabolism pathways in the cell, resulting in the extinction of microorganisms. The mode of action of the compounds may involve the formation of a hydrogen bond through the azomethine group (>C=N–) with the active centers of various cellular constituents, resulting in interference with normal cellular processes [21, 22]. Heterocyclic compounds do play an important role in regulating biological activities [23-25]. This is further evidenced when vanillin and 4-aminoantipyrine based Schiff base metal complexes shows good antibacterial activity as they contain heterocyclic group [11]. Comparatively, this activity is highly enhanced for the metal complexes formed from vanillin based dihydropyrimidone heterocyclic product and 4-aminoantipyrine. The antimicrobial activity of the complexes follows the order Hg<Zn<Cu, which may be due to the increasing stability of the complexes [26].
In vitro cytotoxicity
The in vitro cytotoxicity was evaluated after 24 hr incubation of the synthesized compounds at increasing concentration with the normal and cancer cells. Results of the MTT assay are expressed in terms of concentration required for 50% inhibition (IC 50%) graphically and presented in Graph 1. The compounds exhibited cytotoxic activity at a very low concentration against any of 2 cell lines. However, [HgL2]Cl2 was more effective than the cytotoxicity of [CuL2]Cl2 and [ZnL2]Cl2. Cytotoxic activity of [CuL2]Cl2 was slightly higher for cancerous hep 2 cells when compared with the normal vero cell. To determine whether the cytotoxic effect of the compounds was related to the induction of apoptosis, morphology of cells was investigated using the acridine orange staining. As shown in fig. 3, obvious morphological changes were observed in the treated cells as a dose-dependent manner compared to the solvent treated cells. Both cell lines exposed to the compounds exhibited condensed chromatin and appearance of apoptotic bodies as apoptotic indicators. Furthermore, the number of micronucleated and binucleated cells were significantly increased after the treatment with compounds. Furthermore, the effect of [CuL2]Cl2 was found to be stronger than the other compounds even at its lower concentrations. This was consistent with the results of the MTT assay.
Fig. 1: Antibacterial activity in Pseudomonas aeroginosa
Fig. 2: Antifungal Activity in Aspergillus flavus
Table 1: Antibacterial activity data of ligand and complexes
Compound Organisms |
Zone of Inhibition (mm) |
| L | |
| A | |
| E. coli | 5 |
| Vibrio spp. | 6 |
| Staphylococcus aureus | 6 |
| Pseudomonas aeroginosa | 7 |
| Bacillus spp. | 5 |
| Vibrio parahaemolytics | 7 |
| Salmonella spp. | 6 |
| Aeromonas spp. | 7 |
| Klebsiella spp. | 5 |
| Proteus spp. | 7 |
* A-1000 µg, B-750 µg and C-500 µg
Table 2: Antifungal activity data of ligand and complexes
Compound Organisms |
Zone of Inhibition (mm) |
| L | |
| A | |
| Candida albicans | 6 |
| Aspergillus flavus | 6 |
| Pencillium spp. | 7 |
| Aspergillus niger | 5 |
| Trichophyton | 7 |
* A-1000 µg, B-750 µg and C-500 µg
Table 3: Anticancer effect of [CuL2]Cl2 on Hep2 cell line
| S. No. | Concentration (µg/ml) | Dilutions | Absorbance (O. D) | Cell viability (%) |
| 1 | 1000 | Neat | 0.07 | 10.76 |
| 2 | 500 | 1:1 | 0.15 | 23.07 |
| 3 | 250 | 1:2 | 0.22 | 33.84 |
| 4 | 125 | 1:4 | 0.27 | 41.53 |
| 5 | 62.5 | 1:8 | 0.32 | 49.23 |
| 6 | 31.2 | 1:16 | 0.36 | 55.38 |
| 7 | 15.6 | 1:32 | 0.39 | 60.00 |
| 8 | 7.8 | 1:64 | 0.43 | 66.15 |
| 9 | Cell control | - | 0.65 | 100 |

Fig. 3: Anticancer effect of [CuL2]Cl2 on Hep2 cell line

Graph 1: MTT Assay of [CuL2]Cl2 on Hep2 cell line
DNA cleavage
The presence of cells with apoptotic bodies in cultured cells treated with cytotoxic agents was considered as a marker of cell death by apoptosis and linked to DNA fragmentation associated with apoptosis. Typical results from hep 2 cells treated with Hg(II) and Cu(II) are shown in fig. 4. The compound [CuL2]Cl2 induced the DNA fragmentation with a very excited specific activity than the other complexes.


Fig. 4: DNA Fragmentation of [HgL2]Cl2 and [CuL2]Cl2, Lane 1: Control, Lane 2: Concentration-125 µg/ml, Lane 3: Concentration-62.5 µg/ml, Lane 4: Concentration-31.2 µg/ml, Lane 5: Marker (100bp DNA Ladder)
CONCLUSION
The antimicrobial activity is highly enhanced for the metal complexes formed from vanillin based dihydropyrimidinase heterocyclic product and 4-aminoantipyrine. The antimicrobial activity of the complexes follows the order Hg<Zn<Cu. The complex [HgL2]Cl2 was more effective than the cytotoxicity of [CuL2]Cl2 and [ZnL2]Cl2. Cytotoxic activity of [CuL2]Cl2 was slightly higher for cancerous hep 2 cells when compared with the normal vero cell. The effect of [CuL2]Cl2 was found to be stronger than the other compounds even at its lower concentrations. This was compared and concluded with the results of the MTT assay. The compound [CuL2]Cl2 showed the DNA fragmentation with a very excited specific activity than the other complexes.
ACKNOWLEDGEMENT
The authors are thankful to the Principal and the Head of the department, Department of Chemistry, Presidency College for providing necessary facilities to continue with our work. They also acknowledge Director Research, Bharathiar University, Coimbatore for the support in the research. The authors express their sincere thanks to the UGC (9th plan), New Delhi for financial support.
CONFLICT OF INTERESTS
Declare none
REFERENCES
- Fugu MB, Ndahi NP, Paul BB, Mustapha AN. Synthesis, characterization and antimicrobial studies of some vanillin Schiff base metal(II) complexes. J Chem Pharm Res 2013;5:22-8.
- Pradeep PS, Shrungesh kumar TO, Prashantha N, Mahadevan KM. Synthesis, Invitro antibacterial, toxicity and molecular docking anticancer activity of novel N-[(2-chloroquinolin-3-yl) methylidene]-2-aniline schiff bases. Int J Curr Pharm Res 2015;7:37-46.
- Singh K, Barwa MS, Tyagi P. Synthesis and characterization of cobalt(II), nickel(II), copper(II) and zinc(II) complexes with Schiff base derived from 4-amino-3-mercapto-6-methyl-5-oxo-1,2,4-triazine. Eur J Med Chem 2007;42:394-402.
- Chandra S, Sangeetika J. EPR and electronic spectral studies on copper(II) complexes of some N-O donor ligands. J Indian Chem Soc 2004;81:203-6.
- PG Cozzi. Metal–salen schiff base complexes in catalysis: practical aspects. Chem Soc Rev 2004;33:410.
- Canpolat E, Kaya M. Studies on mononuclear chelates derived from substituted Schiff-base ligands (part 2): synthesis and characterization of a new 5-bromosalicyliden-pamino acetophenone oxime and its complexes with Co(II), Ni(II), Cu(II) and Zn(II). J Coord Chem 2004;57:1217.
- Usharani M, Akila E, Jayaseelan P, Rajavel R. Structural elucidation of newly synthesized potentially active binuclear schiff base Cu(II), Ni(II), Co(II) and Mn(II) complexes using physicochemical methods. Int J Sci Eng Res 2013;4:1055.
- Raman N, Sobha S, Mitu L. Design, synthesis, DNA binding ability, chemical nuclease activity and antimicrobial evaluation of Cu(II), Co(II), Ni(II) and Zn(II) metal complexes containing tridentate Schiff base. J Saudi Chem Soc 2013;17:151-9.
- Kannan D, Arumugham MN. Synthesis, characterisation, DNA-binding studies and antimicrobial activity of copper (II) complex with 1,10 phenanthroline, L-tyrosine and thiourea as ligands. Int J Res Controlled Release 2012;2:10-7.
- Meenakshi Jain, Madhuri Modi, Maya Agarwal, Hemant Sharma. Synthesis, free radical scavenging and DNA cleavage activities of some novel Indole derivatives. Int J Pharm Pharm Sci 2015;7:97-103.
- Akhil R Chakravarty. Photocleavage of DNA by copper(II) complexes. J Chem Sci 2006;118:443–53.
- Mangaiyarkkarasi P, Arul Antony S. Synthesis, Characterization and biological significance of some novel schiff base transition metal complexes derived from 4-aminoantipyrine and dihydropyrimidine of vanillin. J Appl Chem 2014;3:997-1006.
- Mangaiyarkkarasi P, Arul Antony S. Synthesis, spectral characterization and antimicrobial studies of some novel schiff base metal complexes of vanillin based dihydropyrimidone heterocyclic product and 4-aminoantipyrine. Asian J Sci Technol 2014;5:340-7.
- Ananthanarayana R, Panikar CKJ. Textbook of Microbiolgy. Orient Longman Ltd, Chennai; 2000. p. 581.
- Louds Magdalin Joy A, Reginald Appavoo M. Antibacterial and antifungal activity of strychnos nux vomica seed extract. Int J Chem Pharm Res 2015;7:1495-9.
- Deepak K Rahi, Aruna S Parmar, Vishal Tiwari. Biosynthesis of silver nanoparticles from fungal root endophytes of sida acuta plant and evaluation of their antibacterial and antibiotic enhancing activity. Int J Pharm Pharm Sci 2014;6:160-6.
- Davison HC, Low JC, Woolhouse MEJ. What is antibiotic resistance and how can we measure it? Trends Microbiol 2000;8:554-9.
- Sambrook J, Frtsch EF, Maniatis T. 2nd ed. Molecular cloning-A laboratory manual; 1989.
- UK Laemmli. Cleavage of structural proteins during the assembly of the head of Bacteriophage‐T4. Nature 1970;227:680-5.
- Nagesh GY, Mruthyunjayaswamy BHM. Synthesis, characterization, antimicrobial, DNA cleavage, and in vitro cytotoxic studies of some metal complexes of schiff base ligand derived from thiazole and quinoline moiety. Bioinorg Chem Appl 2014. Doi:10.1155/2014/314963. [Article in Press]
- Sivakami M, Natarajan B, Vijayachandrasekar M. Synthesis, characterization and biological activity of a new mannich base and its metal complexes. Chem Sci Trans 2014;3:1110-4.
- Ritika M Makhijani, Barhate VD. Synthesis, characterization and study of the microbiological activity of some transition metal ion complexes with [N-(O-methoxy benzaldehyde)-2 –amino phenol] (NOMBAP). Int J Curr Pharm Res 2014;6:26-30.
- Gopal Garg, Ashish Acharya, Kuldeep Patel. Design, synthesis and biological evaluation of some schiff base ligand as antimalarial agents. Int J Biomed Res 2013;4:137-44.
- Jian LV, Tingting L, Sulan C, Xin W, Lei L, Yongmei W. Synthesis, structure and biological activity of cobalt(II) and copper(II) complexes of valine-derived schiff bases. J Inorg Biochem 2006;100:1888-96.
- Joseph J, Nagashri K, Ayisha Bibin Rani G. Synthesis, characterization and antimicrobial activities of copper complexes derived from 4-aminoantipyrine derivatives. J Saudi Chem Soc 2013;17:285-94.
- Agwara MO, Yufanyi MD, Foba-Tendo JN, Atamba MA, Ndinteh DT. Synthesis, characterization and biological activities of Mn(II), Co(II) and Ni(II) complexes of hexamethylenetetramine. J Chem Pharm Res 2011;3:196-204.
How to cite this article
- P Mangaiyarkkarasi, S Arulantony. DNA cleavage, cytotoxic activities, and antimicrobial studies of some novel schiff base transition metal complexes derived from 4-aminoantipyrine and dihydropyrimidone of vanillin. Int J Curr Pharm Res 2016;8(3):43-47